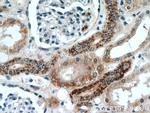
TIMM50 Antibody in Immunohistochemistry (Paraffin) (IHC (P))

Search
Proteintech
TIMM50 Polyclonal Antibody
{{$productOrderCtrl.translations['antibody.pdp.commerceCard.promotion.promotions']}}
{{$productOrderCtrl.translations['antibody.pdp.commerceCard.promotion.viewpromo']}}
{{$productOrderCtrl.translations['antibody.pdp.commerceCard.promotion.promocode']}}: {{promo.promoCode}} {{promo.promoTitle}} {{promo.promoDescription}}. {{$productOrderCtrl.translations['antibody.pdp.commerceCard.promotion.learnmore']}}
产品信息
22229-1-AP
种属反应
宿主/亚型
分类
类型
抗原
偶联物
形式
浓度
规格
纯化类型
保存液
内含物
保存条件
运输条件
产品详细信息
Immunogen sequence: GNNPVDENG AKIPDEFDND PILVQQLRRT YKYFKDYRQM IIEPTSPCLL PDPLQEPYYQ PPYTLVLELT GVLLHPEWSL ATGWRFKKRP GIETLFQQLA PLYEIVIFTS ETGMTAFPLI DSVDPHGFIS YRLFRDATRY MDGHHVKDIS CLNRDPARVV VVDCKKEAFR LQPYNGVALR PWDGNSDDRV LLDLSAFLKT IALNGVEDVR TVLEHYALED DPLAAFKQRQ SRLEQEEQQR LAELSKSNKQ NLFLGSLTSR LWPRSKQP (190-456 aa encoded by BC121147)
靶标信息
TIMM50 (Mitochondrial import inner membrane translocase subunit TIM50) is an enzyme that in humans is encoded by the TIMM50 gene. Tim50 is a subunit of the Tim23 translocase complex in the inner mitochondrial membrane. Mutations in TIMM50 can lead to epilepsy, severe intellectual disability, and 3-methylglutaconic aciduria. TIMM50 expression is increased in breast cancer cells and decreased in hypertrophic hearts.
仅用于科研。不用于诊断过程。未经明确授权不得转售。
生物信息学
蛋白别名: homolog of yeast Tim50; MGC102733; Mitochondrial import inner membrane translocase subunit TIM50; similar to translocase of inner mitochondrial membrane 50 homolog; Tim50-like protein; translocase of inner mitochondrial membrane 50 homolog
基因别名: 2810403L02Rik; AU015082; MGCA9; PRO1512; TIM50; TIM50L; TIMM50
UniProt ID: (Human) Q3ZCQ8, (Mouse) Q9D880
Entrez Gene ID: (Rat) 687295, (Human) 92609, (Mouse) 66525